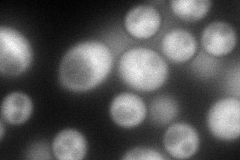
YOR281C
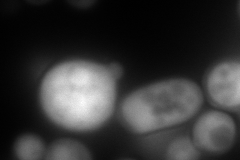
YOR281C
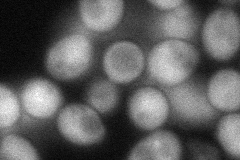
YOR281C
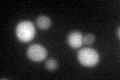
YOR281C
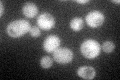
YOR281C
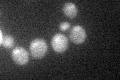
YOR281C

View description
Essential protein that interacts with the CCT (chaperonin containing TCP-1) complex to stimulate actin folding; has similarity to phosducins; null mutant lethality is complemented by mouse phosducin-like protein MgcPhLP
Localization:
Intensity:
Fold change:
Significance:
-
C’ GFP library in SD

cytosol46.22 -
N' NOP1pr-GFP in SD
cytosol135.585 -
N' TEF2pr-mCherry in SD
nucleus243.74 -
N' NATIVEpr-GFP in SD

cytosol63.9078 -
N' TEF2pr-VC and Cyto-VN in SD
cytosol64.76 -
C’ GFP library in SD+DTT
cytosol43.090.93No -
C’ GFP library in SD+H2O2
cytosol50.721.09No -
C’ GFP library in Starvation Media
nucleusN/AN/AYes -
C’ GFP library on the background of Pup2-DaMP

cytosol -
C’ GFP library on the background of CCT mutant

cytosol51.38261.11163No
